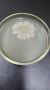
Новинка для сада: Как изоляты Новоспорин Голд помогут вашим растениям

Они появляются!
Посмотрите, на деревьях и кустах уже маленькие листики! Это апрель уверенно зашел в наш город.
Покажите свой апрельский город в комментариях! Где самые красивые цветы и самые большие лужи?
© Фото: телеканал ТОЛЬЯТТИ 24
Подпишись на наш канал в МАХ и будь в курсе всех новостей!